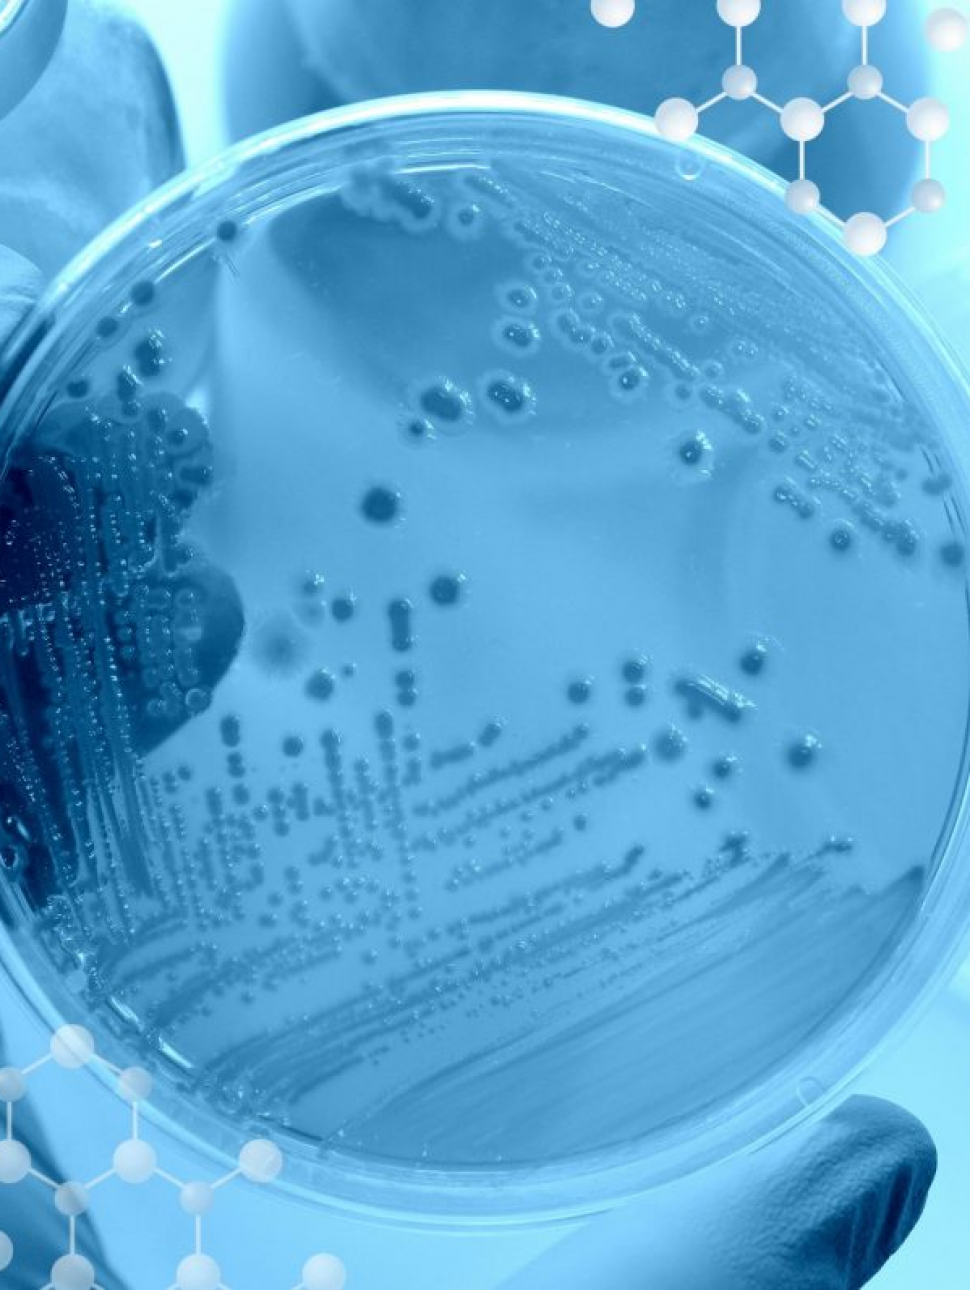
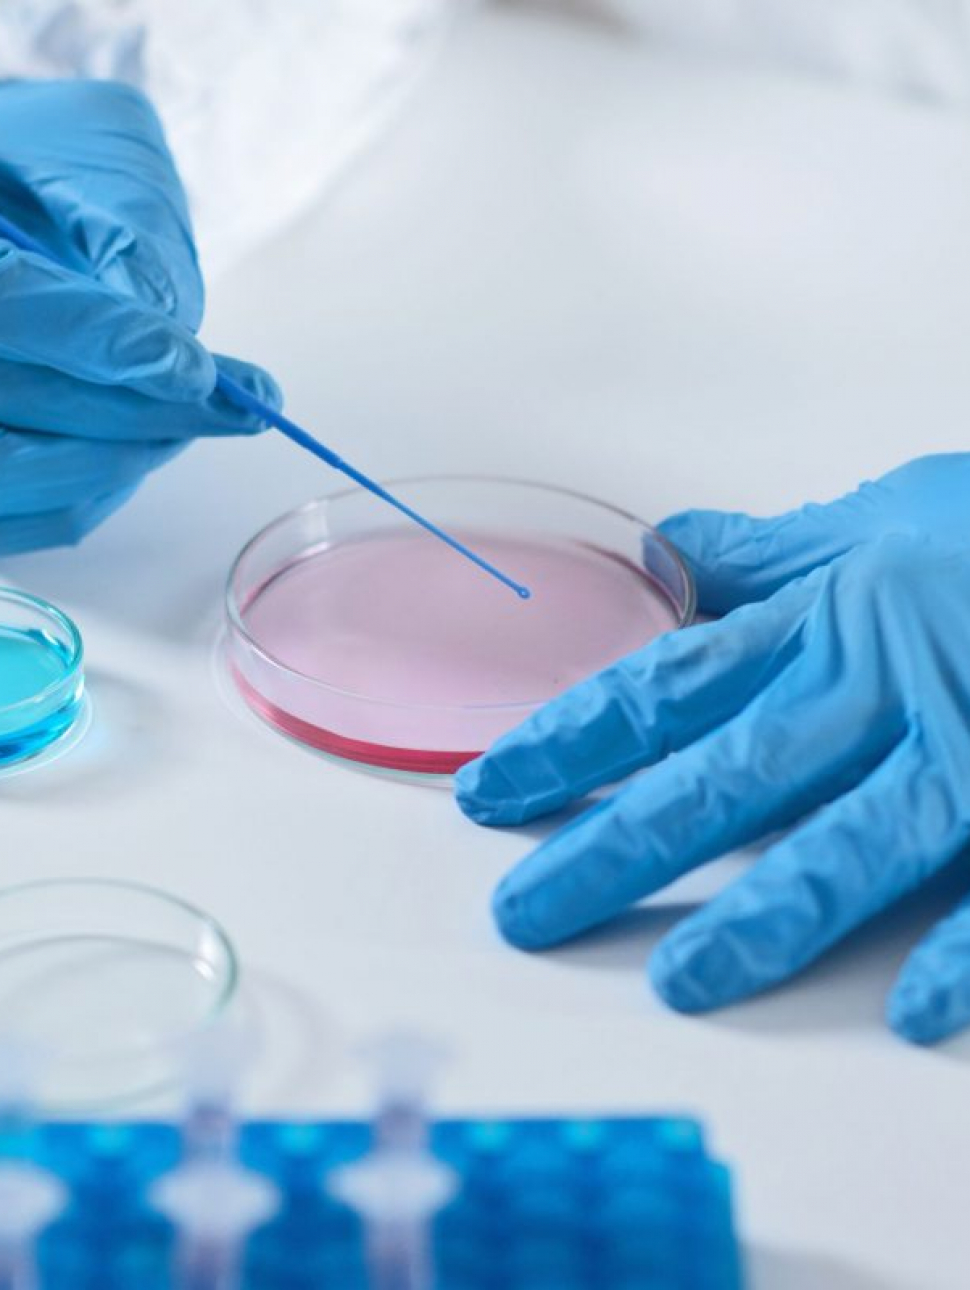

Blog
Per scoprire e conoscere tutte le news sul microbioma, e in particolare su probiotici e nutraceutici, leggi gli articoli del nostro blog.
Come modulare il microbiota intestinale
Perché è importante modulare il microbiota intestinaleModulare il microbiot ...
Asse intestino-cervello, di cosa si tratta?
Asse intestino-cervello, di cosa si tratta?Come avviene la comunicazione? Asse ...
Disbiosi e problemi intestinali in vacanza
Disbiosi e problemi intestinali in vacanzaCosa fare? L’intestino è u ...
Estate e probiotici: 3 regole
Cosa sono i probioticiEstate e probioticiQualche consiglioAlimentazione e p ...
Cosa sono i postbiotici?
Avete mai sentito parlare di "postbiotici"?Cosa sono i postbiotici e da cosa de ...
Qual è la differenza tra virus, microrganismi e batteri?
Qual è la differenza tra virus , microrganismi e batteri?VirusTerminologiaCosa ...
La disbiosi intestinale in età neonatale
Il microbioma intestinale ha un ruolo molto importante per la nostra salute, fi ...
Cosa sono i simbiotici?
Si sente spesso di parlare di prebiotici e probiotici, ma cosa sono i simbiotic ...